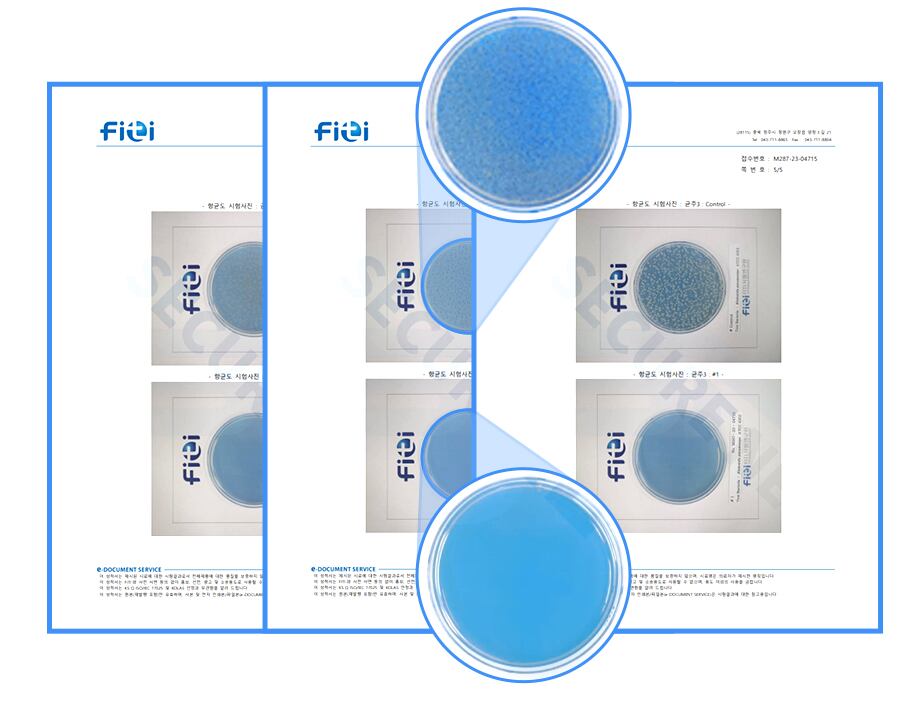

Chosun Mall memperkenalkan produk berkualitas dengan tidak perlu khawatir tentang pembayaran, pertukaran, pengembalian, atau layanan purna jual untuk membantu perusahaan manufaktur dan distribusi lokal memperluas saluran penjualan mereka serta memberikan manfaat eksklusif kepada pembaca. fig0
Saat membuang air ke toilet, tetesan air dapat menyembur lebih dari 3 meter dan menyebar ke segala penjuru. Ada juga kekhawatiran bahwa bakteri yang berkembang biak di dalam toilet bisa menyebabkan berbagai penyakit. Inilah sebabnya mengapa bahkan pembersihan yang sangat teliti sering kali meninggalkan perasaan tidak nyaman.
Pembersih toilet otomatis Holmes Living adalah produk yang praktis yang menghilangkan kekhawatiran tentang pembersihan—cukup letakkan di dalam tangki dan buang air. Produk ini mensterilkan, menghilangkan bau, dan mengatasi noda air. Dijual dengan harga 9.000 won Korea per unit, Chosun Mall menawarkan unit tambahan dengan harga khusus. Satu unit dapat digunakan sekitar 2.500 kali (20 kali buang air per hari), dan tahan sekitar 4 bulan.
Kekurangan terbesar dari pembersih jenis padat yang larut adalah sisa. Potongan yang tidak larut mengapung di sekitar, menciptakan kekacauan. Pembersih Toilet Holmes adalah jenis cairan yang mengalir keluar, sehingga tidak meninggalkan kontaminan atau gumpalan.
Saat bak toilet terisi air, hanya jumlah larutan yang diperlukan secara tepat yang dilepaskan. Setelah konsentrasi tertentu tercapai, tidak ada lagi larutan yang mengalir, memastikan tidak ada sisa dan pengelolaan yang hemat.
Pemasangan sederhana. Lepaskan stiker dan tutup yang terpasang, lalu letakkan produk di tepi bak toilet. Ini bekerja dengan semua toilet yang memiliki bak.

Setiap kali buang air, toilet secara otomatis dibersihkan. Anda dapat menikmati toilet yang selalu bersih setiap hari. Ini secara praktis membersihkan area yang sulit dijangkau seperti bak dan pipa.
Ini secara efektif menghilangkan bakteri berbahaya seperti E. coli dan Staphylococcus aureus yang menyebabkan penyakit menular. Kemampuan sterilisasinya telah diakui oleh Institut Pengujian dan Penelitian FITI.
Ini juga telah lulus sertifikasi untuk tidak mendeteksi zat-zat berbahaya seperti formaldehida, benzena, dan metoksi.
Bekerja dengan semua jenis toilet gaya Barat yang memiliki bak penampung. Jenis umum meliputi toilet dua bagian, satu bagian, dan toilet jongkok. Namun, tidak dapat digunakan pada toilet terintegrasi atau tertutup rapat tanpa bak penampung.


Hilangkan stiker penanda dan tutup plastik di bagian atas, lalu letakkan produk di tepi bak toilet.
Satu unit Holmes Living Toilet Cleaner setara dengan kapasitas 40 pembersih padat. Dapat digunakan sekitar 2.500 kali. Untuk rumah tangga satu orang, tahan hingga 4 bulan, menawarkan efisiensi biaya yang sangat baik.
Anggota Keanggotaan Chosun dapat menggunakan poin mereka untuk membeli dengan harga yang lebih terjangkau dengan mengklik tautan di bawah ini.
Harga produk yang diperkenalkan dalam artikel ini mencakup komisi penjualan yang diperlukan untuk operasional Chosun Mall.
Mereka yang tertarik memperkenalkan produk atau layanan inovatif dapat mengirimkan informasi melalui email (pyy@chosun.com)!



